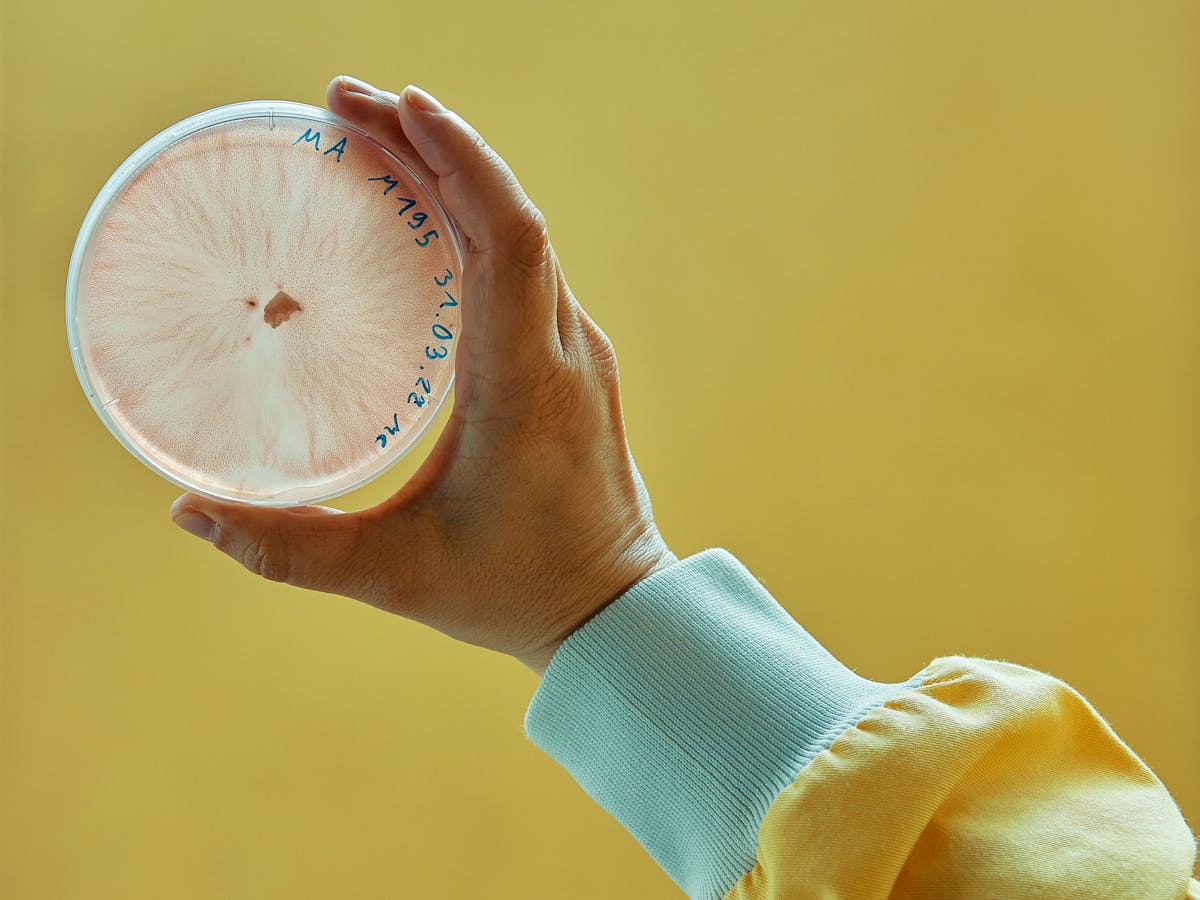
content-image
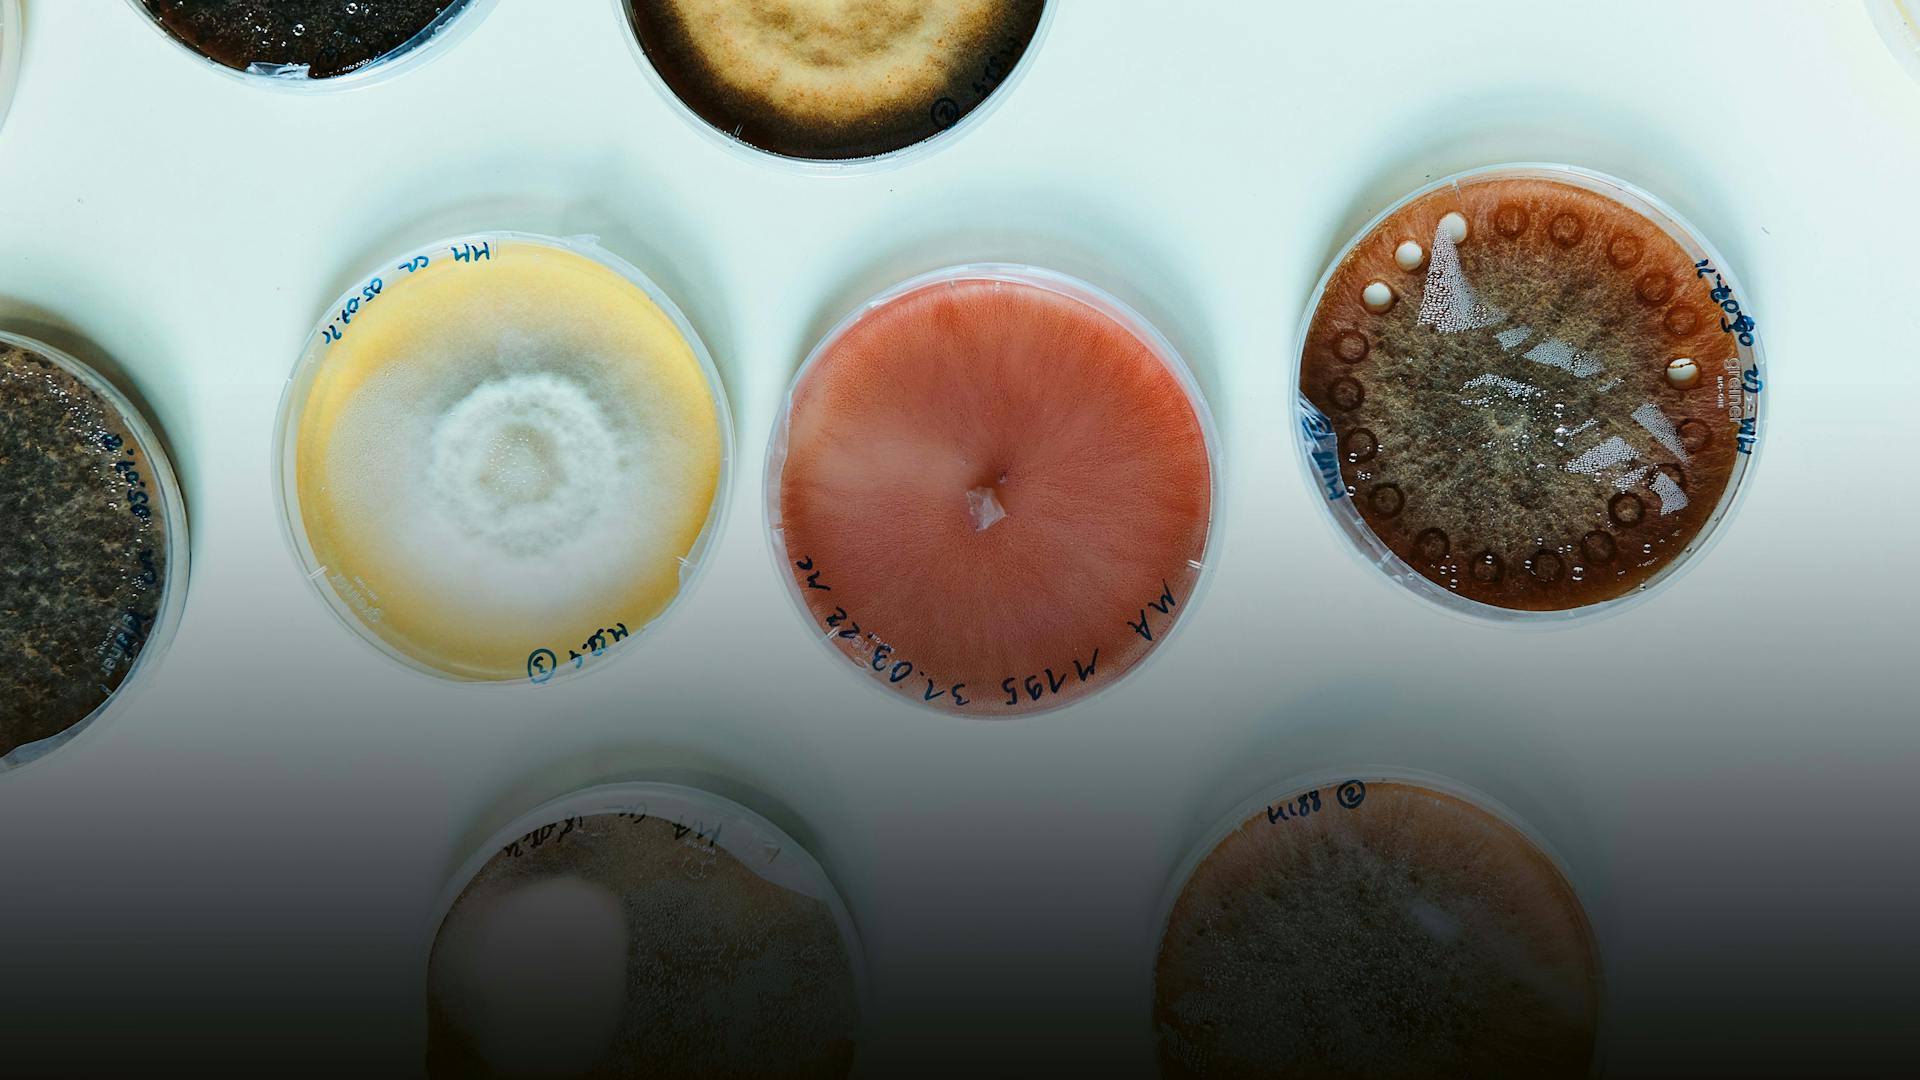
content-image

Table of contents
Table of contents Healthy games
Healthy games Cartilage repair
Cartilage repair Finding impurities
Finding impuritiesPublished on 30/09/2022
Playing video games to improve cognitive health has the potential to help people train their minds in an enjoyable, convenient, and more effective way. Cognitive decline affects most people as they age, as well as being a common symptom of traumatic brain injury and diseases such as Alzheimer’s and Parkinson’s. There are no cures for these conditions, but cognitively stimulating games can help slow the decline. Through such games, physicians – who usually only see patients once or twice a year – could also have a more continuous and unbiased picture of their patients’ progress. Despite these potential benefits, no clinically validated games have made it to the market yet. This is because developing effective games and proving their benefit have been significant challenges for this field – challenges which Prabitha Urwyler aimed to meet with her recent FreeNovation Award.
At the time Urwyler received this award in 2018, she was leading cognitive training research at the University of Bern, ARTORG Center for Biomedical Engineering Research, Gerontechnology & Rehabilitation. Through collaborations with the neighboring memory clinic, her project first held focus groups to confirm which types of games participants enjoyed most (puzzles and strategy games). From there, Urwyler’s team custom-designed two games to train specific cognitive skills – a matching game for visual search and a maze game for spatial navigation. To make sure that the games adapted and continuously challenged the players, the team incorporated AI algorithms as well. Removing bias from the results being another priority, Urwyler ensured that these games were language-free so that native speakers of any language could still readily understand and play the game. When the time finally arrived to test the games in a clinical setting, the project faced the unforeseen challenges of the COVID-19 pandemic. But with some further adjustments, such as mailing gaming tablets and giving instructions over the phone, Urwyler still completed a small proof-of-concept study. The results were successful enough for the project to be now discussing the next steps. A revised feasibility study and a large international clinical trial are now planned with new engagement features in a broader product suite by startup Neurometry with its clinical and research partners.
Boosting blockchain
Blockchain technology – which offers the hope of making digital systems extremely safe – may still be an arcane field for most. But a cross-functional Novartis team is convinced this digital tool has the power to transform the pharmaceutical industry and make drug delivery safer and engagement with patients more direct and personal, among many other things.
This was the idea when Marco Cuomo and Daniel Fritz embarked on a pan-European research project in 2018, which four years down the road is bearing the first fruits and could turn into a bigger, industry-wide association next year.
“When we looked into the possibility of leveraging blockchain technology, we quickly realized that we can only do this with both strong internal support and external partners – blockchain is a team sport,” says Cuomo. “That’s when we contacted Gwenaelle Nicolas, who helped us set up a project with the European Union’s Innovative Medicines Initiative.
The project, known as PharmaLedger, attracted a lot of industry interest early on. Today, it includes nearly 30 organizations, among them 12 pharmaceutical companies. It is a network of some 200 people, who have since been working flat out to lay the groundwork for introducing the technology.
With strong support from Novartis Technical Operations, the team has paved the way for the introduction of electronic product information, which could eventually replace the paper package leaflet that accompanies every pack, not only saving money but also reducing waste and our carbon footprint. Pilots are planned for 2023.
“The key challenge of blockchain technology is to prove the value for the industry to adopt it more broadly,” says Cuomo. “It takes a lot of convincing.”
The team believes that their efforts are worthwhile, and that the collaboration will pay off in the years to come. For this reason, they have set up a non-profit, Switzerland-based association, which will continue the IMI project into the future. Now they are working to attract partners to the association.
“There are many things for which blockchain could be a game changer,” Fritz says. “Once the electronic product information is a reality, it will be possible to update it real-time or provide patients with recall or other information such as how to dispose of the product. We are also working on solutions to tackle counterfeiting, among many other things.”
Precision medicine
While a cure for cystic fibrosis (CF) is not yet available, there are several drugs on the market that help keep potentially life-threatening conditions associated with CF at bay, thereby allowing patients – who are particularly prone to bacterial lung infections – to lead longer and healthier lives. With a range of therapeutic agents in development targeting the disease’s underlying molecular defects, medical care for CF is likely to improve even further.
One major obstacle in treating CF has been the vast variability of the mutations that affect the gene encoding the CF transmembrane conductance regulator (CFTR) protein. So far, over 2000 CFTR mutations have been identified, which result in distinct clinical phenotypes. As such, there is a need for an accurate and rapid diagnostic tool to help clinicians determine which drug works best for the patient.
To alleviate this problem and help clinicians provide individually tailored treatments to people with CF, Nathalie Brandenberg, a researcher at École Polytechnique Fédérale de Lausanne (EPFL) who was awarded a FreeNovation grant in 2017, is currently working on a bioengineered rectal organoid system designed to serve as a surrogate readout in assessing therapeutic effectiveness.
Rectal organoids are in vitro primary stem cell cultures. Brandenberg and her team generate them from patients with CF to study individual responses to authorized CFTR-modulating drugs.
“In other words, depending on the organoids’ response, targeted treatment regimens can be offered to patients,” says Brandenberg, who is in charge of the project based at EPFL. Her team first successfully derived intestinal epithelial organoids from mice, before moving on to human trials.
“Our research lies within the domain of translational medicine, as we strive to connect basic research with medical practice,” Brandenberg says. Reflecting on her work from a clinical vantage point, she adds: “Organoids, which serve as models, enable us to pinpoint and tailor the most effective therapeutic approach – especially for those patients with rare CFTR mutations who lack therapy options.”
Once the trials are complete, Brandenberg and her team aim to take their in vitro diagnostic test to a commercial scale, which would allow CF patients to gain better access to innovative treatments – in a minimally invasive and cost-effective way.